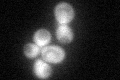
YOR173W
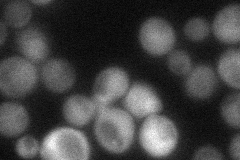
YOR173W
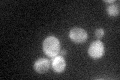
YOR173W
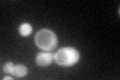
YOR173W

View description
Non-essential, stress induced regulatory protein containing a HIT (histidine triad) motif; modulates m7G-oligoribonucleotide metabolism; inhibits Dcs1p; regulated by Msn2p, Msn4p, and the Ras-cAMP-cAPK signaling pathway, similar to Dcs1p.
Localization:
Intensity:
Fold change:
Significance:
-
C’ GFP library in SD
cytosol39.14 -
N' NOP1pr-GFP in SD

cytosol142.519 -
N' TEF2pr-mCherry in SD

cytosol168.065 -
N' NATIVEpr-GFP in SD
cytosol46.5176 -
N' TEF2pr-VC and Cyto-VN in SD

cytosol55.5796 -
C’ GFP library in SD+DTT

cytosol40.031.02No -
C’ GFP library in SD+H2O2
cytosol581.48Yes -
C’ GFP library in Starvation Media
cytosol102.012.6Yes -
C’ GFP library on the background of Pup2-DaMP

cytosol -
C’ GFP library on the background of CCT mutant

cytosol50.7211.29568No
